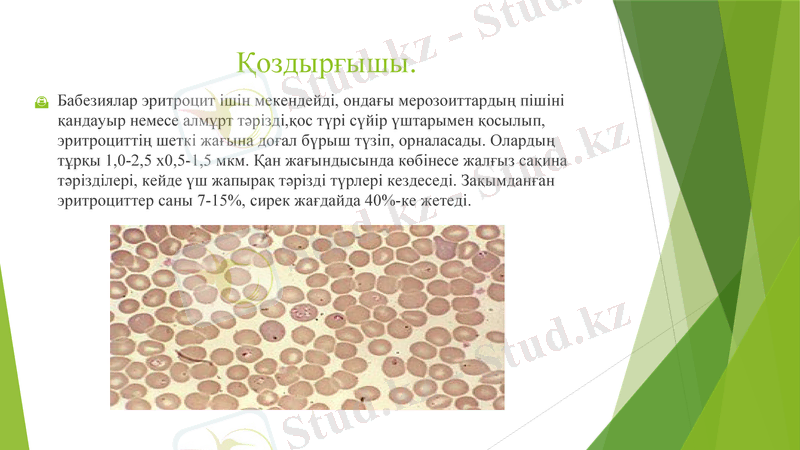
Slide 4

Ірі қара малдағы бабезиоз бен франсаиеллез: қоздырғыштары, эпизоотологиясы, клиникасы, диагнозы, емі және алдын алу



Ірі қара мал бабезиозы мен франсаиеллезі
Қазақ Ұлттық Аграрлық Университеті
Ветеринария факультеті

Жоспар:
1. Ірі қара бабезиозы.
Қоздырғышы.
Эпизоотологиялық деректер
Ауру белгілері
Өлекседегі өзгерістер
Диагноз
Емі
Аурудан сақтандыру шаралары
2. Ірі қара франсаиеллезі
Қоздырғышы
Эпизоотологиялық деректер
Ауру белгілері
Емі және дауасы

Ірі қара бабезиозы
Бабезиоз - жіті өтетін, мал денесінің қызуымен, гемоглобинуриямен, анемиямен және кілегей қабықтарының сарғыштануымен, жүрек-қан тамыр, асқазан жүйелері қызметісипатталатын трансмиссивті ауру.
Қоздырғышы.
Бабезиялар эритроцит ішін мекендейді, ондағы мерозоиттардың пішіні қандауыр немесе алмұрт тәрізді, қос түрі сүйір үштарымен қосылып, эритроциттің шеткі жағына доғал бүрыш түзіп, орналасады. Олардың тұрқы 1, 0-2, 5 x0, 5-1, 5 мкм. Қан жағындысында көбінесе жалғыз сақина тәрізділері, кейде үш жапырақ тәрізді түрлері кездеседі. Зақымданған эритроциттер саны 7-15%, сирек жағдайда 40%-ке жетеді.

Қоздырғыштың биологиясы
Ірі қара мал организмінде бабезиялар эритроцитте қарапайым әдіспен екіге немесе бүртіктеніпбөліну арқылы көбейеді. Кейде бабезияларды эритроциттен тыс плазмада көруге болады. Олардың кене денесінде көбеюі толыкзерттелмеген. В. bovis-ті үш иелі Ixodes ricinus және L persulcatusкенелері тасымалдайды.
Кенелер ауру немесе ауырып жазылған жануарлар қанымен қоректеніп, бабезияларды кабылдайды Кенеденесіне енген паразиттер алдымен оның ішегінде карапайымәдіспен бөлініп, соңынан 2-4-6 ядрола торша түзеді. Мундай бабезиялар ішек эпителийіне еніп, көп болшекке бөлінеді де, коп ядролыторша түзеді. Соңғылар ыдырап, тағы бірнеше рет болиеді Будан кейін, түзілген гүрзі тәрізді торшалар, гемолимфаға еніп, кененіңәртүрлі мүшелері мен ұлпаларына тарайды.
Сонымен катар, па-разиттер жүмыртка уызына еніп, онда олар тағы да көбейеді. Кене жүмыртқаларынан шыккан баланкенелерде және одан дамыган нимфа мен имаго сатысында бабезиялар бар. Олар кене организміне таралып, сілекей бездеріне енеді. Ixodes кенелері мал канынсору кезінде, бабезияларды сілекейімен берге канға енгізеді.

Қоздырғыштың эритроцитте өсіп өну стадиялары

Эпизоотологиялық деректер.
Бабезиозға ірі қараның барлық тұқымдары бейім. Ауру Ресейде, Балтық бойындағы республикаларда, Батыс Украинада кездеседі. Қазақстанда да бул ауру кездеседі деген деректер бар. Бабезиоз ауруының таралуы I. ricinus кенесінің таралу ареалына байланысты.
Бүл кенелер бұталы жерлерде, бүта жоне усак орман алқаптарында өмір сүреді. Кенелермал канын Онтүстікте кокек-мамырда, ал Солтүстікте мамырмаусым айларынан сора бастайды. Ауру белгісі мамыр айынын ортасынан бастап білінеді.
Аурудың ең көп шығатын айы маусымжәне шілденің басы, онан соң олардың саны бірте-бірте азаяды. Кейбірде ауруға шалдыққан мал тамыз-қыркүйек айларында, кейдеқазан айында да кездеседі. Энзоотиялык алката бабезиоз мозаикатәрізді тараған. Бабезпозбен ересек мал ауыр түрде ауырып, оған карагандамал толінде індет жеңілдеу өтеді. Энзоотиялык ошактарда 1-2жастагы жас мал кейде қатты ауырады.

Ixodes Ricinus кенесінің дамуы

Ауру белгілері.
Аурудың алғашқы белгілері жануарларды кенелі жайылымға шығарғаннан кейін 12-14 күнен соң білінеді. Кобінесе жануарларда дене кызбасы котерлер алдында сауымышүғыл томендейді. Мүндайда сүттің түсі сарғыш тартып, дәміащы болады. Дене қызбасы 41-42°С дейін котеріледі, 2-3 күнненсон мал денесі солтын тартып жатып алады, жемнен бас тартканымен, су ішеді. Тыныс алуы 1 мин ішінде 70-80-ге дейін жиілейді. Жүрек согысы күшейеді. тамыр соғысы мин инде 90-100ге дейін жиілеп, оның ырғағы бүзылады. Кейде көк тамыр соғуын коруге болады. Алғашқыда несеп кызгылт түсті, соңынан сонкызыл-қоңыр түске айналады (гемоглобинурия) Несеп шығарукиындап сиырлар белін букірейтеді Несеп токтағанда сиырлардыңбулшык етi дірілдейді. Несепте кан немесе от пигменттері, бедок, хлоридтер мен фосфордын коп жиналуы байқалады.

Көздін, сондай-ақ мүрын және ауыз куыстарынын, жынысмушелерінін кілегей кабыктары сарғыштанады, аурудын жпітуриде олар катталайды. Аурудың алғашқы күндерінде жануарлардын іші өтеді, сонынан мес карнында атония дамиды. Тезегікургак, шырышты.
Қаны сүйылып, эритроциттер саны 2 млн-ға дейін, гемоглобин30%-га дейін азаяды. Қан курамында айрықша өзгерістер болып, эритроциттер анизоцитозга, пойкилоцитозга, .
Қызбаның алдыңғы күндерінде канда паразиттер пайда болады. Буаз сиырлар іш тастауы мүмкін. Кейде талақ жарылуынан малөліп қалады. Аурудың жеңіл түрінде (көбінесе жас малда) гемоглобинурия пайда болады. Кейін 3-4 куннен сон кызба төмендеп, несеп молшрлене бастайды. Малдын жем-шөпке ынтасы калыптасып, бірте-бірте қан көрсеткіштері де 2-3 айдан соң ғана қалпынакеледі. Сүт шығымы бұзаулағаннан соң гана калпына келеді Өлім-жітім 30%-ға дейін жетеді. Емді дүрыс және ерте жүргізсе, малшығыны болмауы мүмкін

Өлекседегі өзгерістер.
Көрінген кілегей қабықтары бозарғанжәне сарғыш тарткан. Тері астындағы шелi сарғайған, нүкте тәрізді қан күйылған. Бауыры ұлғайған, түсі сары балшык тәрізді, ұлпасы тыгыз. Өт калтасы кою, түйіршікті, қоңыр-жасыл өтке толы. Жалбыршақ қарын құрғақ. Ұлтабары жартылай бос Ултабар, ашы және жуан ішектерінің кілегей қабықтары қалындаған. қызарған және кан күйылған.
Талағы екі және одан да көп есе үлкейген, кесіп көргенде шырышты, улпасы жумсак, қабык асты канталаған. Ол жарылған жағдайда кұрсақ іші ұйыған қанға толы. Сондай-ак бүйректері деүлкейген, үлпасы босаңсыған, оның қабаттарының шекарасы жойылған. Қуығы кызыл несепке толы, кiлireй кабыктары кызарғанжане канталаған.
Жүрегі үлкейген. бұлшық еттері босансыган, сүр немесе сурКызғылт түсті. Эпикард нүкте немесе дак тәрізденш канталаған.

Диагноз
Диагноз қою үшін эпизоотологиялык, клиникалық зерттеулержүргізіліп, сондай-ак патанатомиялык (өлекседегі) өзгерістер еске алынады. B. Bovis-ті табу үшін кан жағындыларын міндетті түрде зерттеу шарт.
Бабезиозга диагноз койгандла огаи клиникалық белгілері ұқсас караталак, лептоспироз және гематурия сиякты аурулардан ажырата білу керек

Емі
Ауру малды жайылымға шығармай, колла күткен жөн. Жеңіл корытылатын балауса шөп, тартылған жем-шөп Кожесіжана сауылан сут, кок сүт және су беру кажет. Себебі мал жиі шөліркейді. Жүрек кызметін бакылауга алып, кофеин, камфора дәрілерін қолдану кажет. Ішек-карын жолдарының қызметі бұзылғанда, іш айдайтын глаубер тұзын (240-300 г) береді. 10-ті хлорлы натрийді 0, 5 мл/кг дозада күре тамырға жібереді.
Арнайы химиялык препараттардан батризии, неоазидин, азидин, беренил дәрілерінің біреуі 0, 0035 г/кг есебімен 7% ерітінді түрінде етке немесе тері астына жіберіледі. Осы стерилді дистилденген суда ерітеді. Препараттарды кайталап 24-48 caғ coң егеді.

Аурудан сақтандыру шаралары
Аурудан сақтандыру шаралары екі бағытта жүргізіледі.
Біpіншiсі- тасымалдаушы кенелермен күрес. Кене тараған жайылымдарга мал жаюға болмайды. Мәдени жайылымдар малды кене талауынан корғайды. Ауру кездесетін шаруашылыктарда кенелерді өз биотоптарында жоюмен катар, акарацидті препараттармен малды дәрілеу кажет.

- Іс жүргізу
- Автоматтандыру, Техника
- Алғашқы әскери дайындық
- Астрономия
- Ауыл шаруашылығы
- Банк ісі
- Бизнесті бағалау
- Биология
- Бухгалтерлік іс
- Валеология
- Ветеринария
- География
- Геология, Геофизика, Геодезия
- Дін
- Ет, сүт, шарап өнімдері
- Жалпы тарих
- Жер кадастрі, Жылжымайтын мүлік
- Журналистика
- Информатика
- Кеден ісі
- Маркетинг
- Математика, Геометрия
- Медицина
- Мемлекеттік басқару
- Менеджмент
- Мұнай, Газ
- Мұрағат ісі
- Мәдениеттану
- ОБЖ (Основы безопасности жизнедеятельности)
- Педагогика
- Полиграфия
- Психология
- Салық
- Саясаттану
- Сақтандыру
- Сертификаттау, стандарттау
- Социология, Демография
- Спорт
- Статистика
- Тілтану, Филология
- Тарихи тұлғалар
- Тау-кен ісі
- Транспорт
- Туризм
- Физика
- Философия
- Халықаралық қатынастар
- Химия
- Экология, Қоршаған ортаны қорғау
- Экономика
- Экономикалық география
- Электротехника
- Қазақстан тарихы
- Қаржы
- Құрылыс
- Құқық, Криминалистика
- Әдебиет
- Өнер, музыка
- Өнеркәсіп, Өндіріс
Қазақ тілінде жазылған рефераттар, курстық жұмыстар, дипломдық жұмыстар бойынша біздің қор #1 болып табылады.



Ақпарат
Қосымша
Email: info@stud.kz